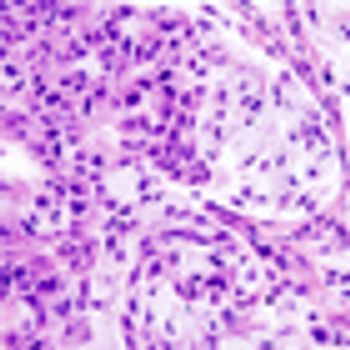

Elective neck lymph node surgery for patients with early oral cancer reduces the risk of cancer recurrence and improves survival.

Your AI-Trained Oncology Knowledge Connection!


Elective neck lymph node surgery for patients with early oral cancer reduces the risk of cancer recurrence and improves survival.

Pembrolizumab demonstrated a 24.8% overall response rate in patients with recurrent or metastatic squamous cell carcinoma of the head and neck.

A new study found that compliance with post-treatment clinical surveillance improved survival outcomes in patients with head and neck squamous cell carcinoma.

A new population-based study has found that patients with thyroid cancer who are treated with radioactive iodine therapy are at increased risk for developing salivary cancer as a second malignancy.

The HPV 16/18 vaccine protects women from cervical, anal, and oral HPV infections that can lead to cancer, including some women previously exposed to HPV.

Vaccinating boys aged 12 years against the human papillomavirus (HPV) may be cost-effective in the prevention of oropharyngeal cancer.

The FDA has approved lenvatinib (Lenvima) for the treatment of patients with progressive, differentiated thyroid cancer refractory to radioactive iodine.

An infection with oral HPV16 is likely to last for a year or longer in older men, putting them at higher risk for the development oropharyngeal cancer.

Cancer survivors are at an increased risk for developing a second smoking-associated cancer if they smoked cigarettes prior to their first cancer diagnosis.

Using tobacco is linked to an increased risk of infection with oral HPV type 16, a sexually transmitted virus known to cause cancers of the mouth and throat.

In patients with recurrent or metastatic head and neck squamous cell carcinoma, afatinib better delayed cancer progression compared with methotrexate, according to results presented at the 2014 ESMO Congress.

Researchers have developed a preliminary test using blood and saliva samples to detect disease recurrence in patients with HPV-related head and neck cancer.

A 74-year-old man presented with a 2.5-cm ulcerated mass occupying the middle third of his left outer ear, approximating the helical rim.

A phase II study demonstrated that cetuximab plus docetaxel-based chemoradiotherapy postoperatively in patients with high-risk squamous cell carcinoma of the head and neck led to improved disease-free and overall survival.

High-risk HPVs may be present more frequently than previously estimated in a variety of head and neck cancers, supporting the use of a combination of methods to detect high-risk strains.

A small retrospective study has identified several biomarkers that were significantly altered in patients with head and neck squamous cell carcinoma. If further validated, these serum biomarkers could facilitate early diagnosis.

Researchers have identified several risk factors that may help predict which patients with oropharyngeal cancer may require a percutaneous endoscopic gastrostomy tube during chemoradiotherapy, according to a newly published review.

Black race did not adversely affect outcomes after receiving radiotherapy for head and neck squamous cell carcinoma compared with white race, according to the results of a study in which black patients made up the majority of enrolled participants.

A new study of the relationship between BRAF V600E mutation status and its effect on papillary thyroid carcinoma found a negative association with clinicopathologic features suggestive of more aggressive disease.

The use of altered fractionation radiotherapy increased overall survival in patients with locally advanced head and neck cancers when compared with standard radiation, according to the results of a meta-analysis presented on Saturday at the 2013 European Cancer Congress in Amsterdam.

Researchers in China have found that the use of [18F] fluorodeoxyglucose PET/CT detected a greater number of distant metastases than conventional work-up imaging in patients with nasopharyngeal carcinoma.

Researchers in Canada have shown for the first time that the incidence of HPV-related oropharyngeal cancers is increasing among the Canadian population.

Neck dissection may no longer be the only surgical option for pathologic staging of the neck in patients with oral cavity squamous cell carcinoma, according to a new study.

More than one-third of patients with oropharyngeal cancer were seropositive for HPV16 E6 an average of 6 years prior to their cancer diagnosis compared with less than 1% of healthy controls, a new study has found.
Researchers have developed and tested a nomogram that uses various factors and can predict risk of recurrence in patients with major salivary gland carcinoma.